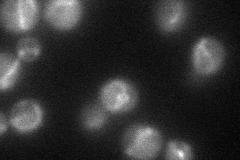
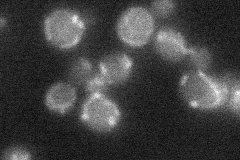
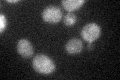
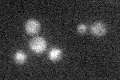

View description
Subunit of the tRNA splicing endonuclease, which is composed of Sen2p, Sen15p, Sen34p, and Sen54p; Sen2p contains the active site for tRNA 5' splice site cleavage and has similarity to Sen34p and to Archaeal tRNA splicing endonuclease
Localization:
Intensity:
Fold change:
Significance:
-
C’ GFP library in SD

mitochondria22.35 -
N' NOP1pr-GFP in SD
mitochondria50.7415 -
N' TEF2pr-mCherry in SD

punctate34.9248 -
N' NATIVEpr-GFP in SD
mitochondria25.7206 -
N' TEF2pr-VC and Cyto-VN in SD

#N/A0 -
C’ GFP library in SD+DTT
mitochondria17.530.78Yes -
C’ GFP library in SD+H2O2

mitochondria18.90.84No -
C’ GFP library in Starvation Media
mitochondria26.451.18No -
C’ GFP library on the background of Pup2-DaMP

mitochondria -
C’ GFP library on the background of CCT mutant

mitochondria22.41171.00254No
